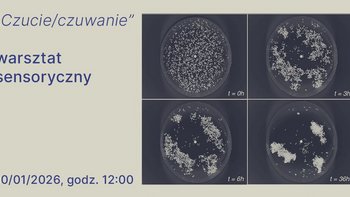

Filtry
sobota, 10 stycznia 2026
Czucie/czuwanie │ warsztat sensoryczny towarzyszący wystawie „Perfumeryzm”
Podczas warsztatu sprawdzimy czy nasze nosy działają tak samo. Do czego może prowadzić kierowanie się węchem. I co, jeśli go stracimy? Zajęcia będą okazją do twórczego, ale i nieco filozoficznego… więcej
10.01.2026 12:00

Warsztaty familijne dla dzieci 4+ i opiekunów w Muzeum Sztuki ms2
W soboty zapraszamy na warsztaty familijne dla dzieci 4+ i opiekunów. Raz w miesiącu otworzymy przestrzeń odpoczynkową w ms² na sobotnie zorganizowane leniuchowanie! więcej
10.01.2026 12:30

Śmigaj na łyżwach w Porcie Łódź
Co znajduje się na Waszej liście zimowych atrakcji? Jeśli jest na niej jazda na łyżwach, to koniecznie wpadnijcie zrobić okrążenia i piruety na lodowisku w Porcie Łódź. więcej
10.01.2026 14:00

Musical "Mamma Mia!" w Teatrze Muzycznym
Matka, córka i trzej domniemani ojcowie… Sophie w tajemnicy zaprasza na swój ślub mężczyzn, z którymi jej matka, Donna, była związana przed dwudziestu laty, licząc na to, że jeden z nich poprowadzi ją… więcej
10.01.2026 14:00

Zwiedzanie wystawy stałej „Walka słowem” z przewodnikiem w „BIBULE” Tajnej Drukarni Józefa i Marii Piłsudskich
W każdą sobotę oraz niedzielę zapraszamy na zwiedzanie wystawy stałej „Walka słowem” z przewodnikiem lub kuratorem. Zwiedzanie może przyjąć formę spaceru przekrojowego po całej ekspozycji lub… więcej
10.01.2026 14:30

Sobótki ręczne | cykl plastycznych Twórczych Warsztatów rodzinnych w Fabryce Sztuki
Zapraszamy na SOBÓTKI RĘCZNE – rodzinne, kreatywne spotkania, podczas których zwykłe przedmioty zmienią się w niezwykłe dzieła sztuki. To czas wspólnej zabawy i twórczości. Tu dzieci są głównymi… więcej
10.01.2026 15:00

Bębenek Festiwal w Przechowalni
Koncert charytatywny na rzecz WOŚP. więcej
10.01.2026 16:00

„Złota rybka" w Teatrze Lalek Arlekin
Spektakl teatralny dla widzów od 3. roku życia. więcej
10.01.2026 16:00

Magic Show - Kamil Scott w Magic Room
Jeśli kochasz rozrywkę na żywo. Jeśli intryguje Cię sztuka iluzji. Jeśli chcesz poczuć magię. To moje nowe Show jest stworzone dla Ciebie! więcej
10.01.2026 17:00



